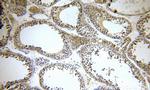
KLHL12 Antibody in Immunohistochemistry (Paraffin) (IHC (P))

Search
Proteintech
KLHL12 Polyclonal Antibody
{{$productOrderCtrl.translations['antibody.pdp.commerceCard.promotion.promotions']}}
{{$productOrderCtrl.translations['antibody.pdp.commerceCard.promotion.viewpromo']}}
{{$productOrderCtrl.translations['antibody.pdp.commerceCard.promotion.promocode']}}: {{promo.promoCode}} {{promo.promoTitle}} {{promo.promoDescription}}. {{$productOrderCtrl.translations['antibody.pdp.commerceCard.promotion.learnmore']}}
产品信息
14883-1-AP
种属反应
宿主/亚型
分类
类型
抗原
偶联物
形式
浓度
规格
纯化类型
保存液
内含物
保存条件
运输条件
产品详细信息
Immunogen sequence: NLLQYVRMP LLTPRYITDV IDAEPFIRCS LQCRDLVDEA KKFHLRPELR SQMQGPRTRA RLGANEVLLV VGGFGSQQSP IDVVEKYDPK TQEWSFLPSI TRKRRYVASV SLHDRIYVIG GYDGRSRLSS VECLDYTADE DGVWYSVAPM NVRRGLAGAT TLGDMIYVSG GFDGSRRHTS MERYDPNIDQ WSMLGDMQTA REGAGLVVAS GVIYCLGGYD GLNILNSVEK YDPHTGHWTN VTPMATKRSG AGVALLNDHI YVVGGFDGTA HLSSVEAYNI RTDSWTTVTS MTTPRCYVGA TVLRGRLYAI AGYDGNSLLS SIECYDPIID SWEVVTSMGT QRCDAGVCVL REK (217-568 aa encoded by BC004175)
靶标信息
Serves as a substrate-specific adapter for the CUL3-based ubiquitin-protein E3 ligase complex. Negatively regulates the Wnt signaling pathway via the targeted ubiquitination and subsequent proteolysis of DVL3.Tissue specificity: Highly expressed in testis and at lower levels in the submandibular salivary gland.
仅用于科研。不用于诊断过程。未经明确授权不得转售。
生物信息学
蛋白别名: CUL3-interacting protein 1; DKIR homolog; FLJ27152; hDKIR; kelch-like 12; Kelch-like protein 12; kelch-like protein C3IP1; unnamed protein product
基因别名: C3IP1; DKIR; KLHL12
UniProt ID: (Human) Q53G59, (Mouse) Q8BZM0, (Rat) Q8R2H4
Entrez Gene ID: (Human) 59349, (Mouse) 240756, (Rat) 266772